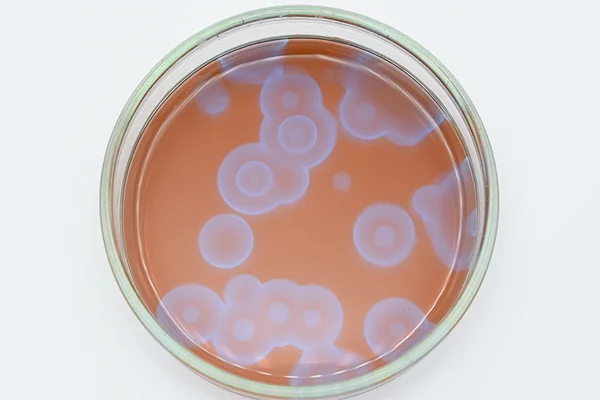
OL2026_03

国立科学博物館の研究施設と標本収蔵施設が茨城県つくば市にあることをご存知ですか?
「科博オープンラボ」は、国立科学博物館筑波地区での研究活動を皆さんに広く知っていただくための企画です。
普段は公開していない研究スペースを年に一回だけ、特別に公開します!
「科博オープンラボ」は、国立科学博物館筑波地区での研究活動を皆さんに広く知っていただくための企画です。
普段は公開していない研究スペースを年に一回だけ、特別に公開します!
2026年3月31日
当選された皆様に、当選通知を送信いたしました。オープンラボ当日は当選通知をご用意いただき、受付のスタッフにお見せいただくようにお願いいたします。
※当選者の方のみに当選通知をお送りしております。落選された方へのご連絡はしておりませんのでご了承ください。
国立科学博物館筑波地区とは?
自然史と科学技術史の研究機関として、動物・植物・生命史・理学の4つの研究部(HTML)(リンクを新しいタブで開きます)と、3つの研究センター、一般公開も行っている筑波実験植物園(HTML)(リンクを新しいタブで開きます)があります。標本収蔵施設には、およそ520万点の貴重な標本・資料が収められています。この筑波地区では、博物館ならではの研究・学習支援活動を活発に進めています。

▲標本収蔵施設のうち自然史標本棟 標本・資料棟には、動物剥製や岩石、人骨、植物などの標本・資料が収蔵されています。
オープンラボ概要
| 公開日 | 2026年4月19日(日) |
| 公開時間 | 10時~15時45分(9時45分受付開始、受付終了14時45分) |
| 開催場所 | 国立科学博物館 筑波地区(HTML)(リンクを新しいタブで開きます)(〒305-0005 茨城県つくば市天久保4-1-1) |
| 参加費 | 無料 |
| 参加方法 | 科博オープンラボは完全事前申込制です。 すべてのツアーは抽選により参加者を決定します。当日受付はありません。 本ページ上にて、下記日程で募集を行います。
|
| 抽選方法と当選に関する
重要なお知らせ | より多くの方にツアーを体験いただくため、以下のルールに基づき厳正な抽選を行います。
必ず下記をご一読の上、お申し込みをお願いします。 1. 当選制限と申し込みグループの取り扱いについて
2. 複数ツアーへのお申し込みについて
以上、あらかじめご理解のうえ、お申込みください。 |
| 備考 | |
| 問い合わせ先 | 国立科学博物館 研究推進・管理課 オープンラボ担当 Mail:outreach@kahaku.go.jp TEL:029-853-8901 |
事前申込が必要なイベント
自然史標本棟 特別見学ツアー
普段は公開を行っていない貴重な研究資料が収蔵された自然史標本棟内を巡り、動植物や植物標本、古生物や鉱物が収蔵されている標本室を、研究員の解説を聞きながら見学します。

| 集合時間 | 9:45 ~ 14:30 |
| 定員 | 各回20名程度 |
筑波実験植物園バックヤードツアー
普段は見られない植物園の裏側をご案内します。絶滅危惧植物の展示解説もあります。

| 開催時間 | 圃場
|
| 定員 | 圃場
|
研究員の植物園スペシャルツアー
植物園の研究員が独自の視点で “とっておき”の植物を紹介します。

| 開催時間 | 13:30 ~ 14:00 |
| 定員 | 30名程度 |
その他のコーナー
産業技術史資料情報センターの活動紹介

産業技術史資料情報センターの活動を、パネルや報告書などを用いて紹介します。
サイエンスミュージアムネットの活動紹介

サイエンスミュージアムネットの活動を、パネルやリーフレット等を用いて紹介します。
模様の化学反応実演・解説
自然と模様があらわれる化学反応について実演・解説します。
爬虫両生類標本を観察しよう

液浸標本を利用して爬虫両生類の多様な形態や生態を紹介します。
標本づくりの技! -海の哺乳類編-

イルカやアザラシなど海の哺乳類の標本作りを実演・解説します。